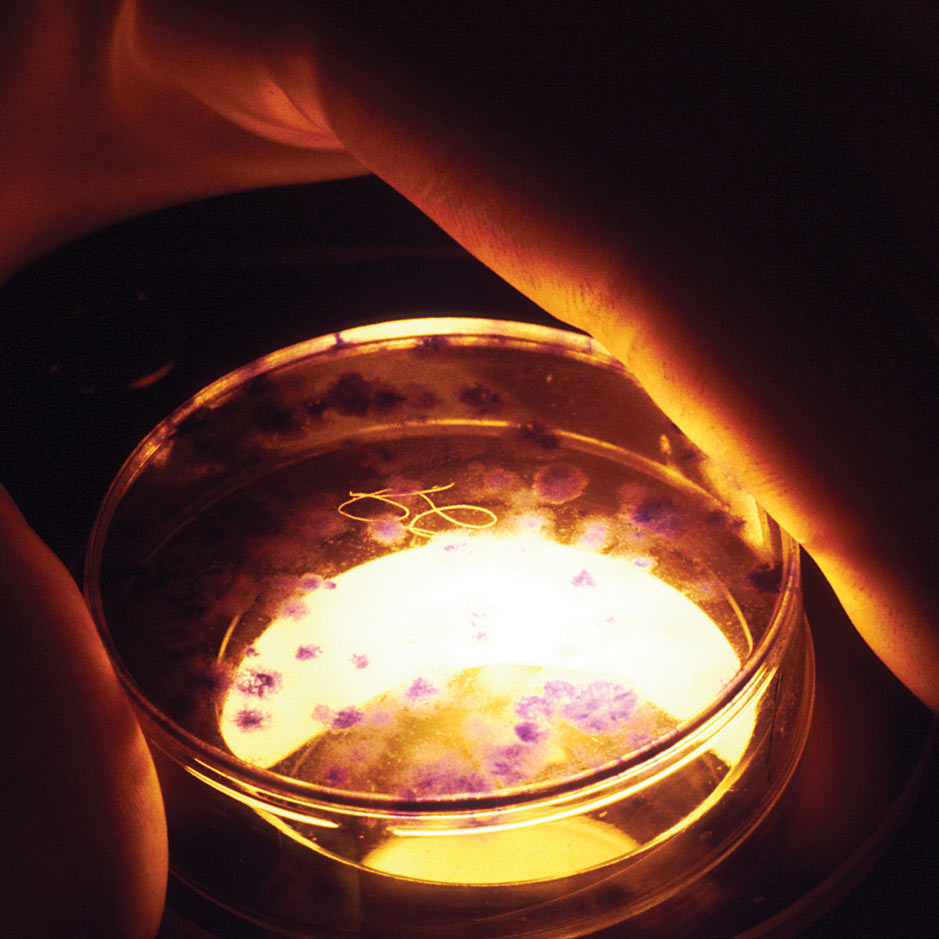
And Baby Makes Four

The decision by the British government earlier this summer to approve a suite of new technologies that would make possible the creation of human embryos with three genetic parents has brought a long-simmering and seemingly obscure bioethical debate into the public eye, raising questions not only about the future of human reproductive technologies but also about some practices that have been with us for decades.
The British decision followed recommendations from the country’s Human Fertilisation and Embryology Authority in March of this year and a major bioethics report cautiously endorsing the techniques last year. The debate has muddied the lines between left and right. Liberal groups like the Center for Genetics and Society strongly oppose the new technologies, while some liberal bioethicists like Arthur Caplan have said the new techniques are “worth the ethical risk.” Conservative bioethics commentator Wesley J. Smith, a frequent contributor to these pages, has argued that the new technologies are unethical, while the editors of Real Clear Science, who are scourges of the “antiscientific left,” have endorsed the new technologies.
Recommended Stories
The techniques in question involve transplanting the chromosomes from a single-cell embryo or from an unfertilized egg into a donor egg or embryo from which the chromosomes have been removed. These procedures were developed with a therapeutic intention: They would allow women with mitochondrial disorders to have children who will not inherit those disorders. (Mutations in the mitochondrial DNA can cause a host of serious illnesses.) Unlike in egg or embryo donation, which are methods widely used at in vitro fertilization clinics and would prevent the transmission of these disorders, the children created through the new techniques would be genetically related to the women undergoing the procedure, having inherited her nuclear DNA but not her mitochondrial DNA. What has been most controversial about these techniques is that they would create embryos with three genetic parents: The embryos would inherit chromosomes from one mother and one father, but would also inherit mitochondrial DNA (which contains a small number of additional genes) from the donated embryo or egg cell.
Before focusing on the three-parent issue, let us first look at other objections that have been raised. As Alex Berezow of Real Clear Science notes, some critics “worry about the ethics of destroying embryos,” since one of the new techniques involves the destruction of embryos. But he dismisses this concern by pointing out that “standard IVF also destroys embryos,” which is, unfortunately, all too often true, though this new way of making babies would destroy embryos in a different way from the usual practice of IVF.
The new embryo-destructive technique, known as “pronuclear transfer,” involves an early-stage embryo—one in which the chromosomes from the egg and sperm have not yet joined together in a single nucleus. The pronuclei are extracted, destroying that embryo. The extracted genetic material is then transferred into another, similarly enucleated (and thus destroyed) embryo, but one that was created using a donated egg, thereby creating a new embryo that contains the chromosomes of the man and woman who intend to become parents, as well as the mitochondrial DNA of the egg donor. The destruction of embryos in ordinary IVF results from the discarding of “excess” embryos, or of embryos deemed genetically defective following screening tests. This new technique would be the first assisted-reproductive technology involving the deliberate destruction of human embryos as a necessary part of the procedure.
Berezow is of course correct that countless human embryos are destroyed on a regular basis as a result of the way IVF is practiced in the United States today. That might also lead us to ask whether we have been right to tolerate the cavalier destruction of embryos as just part of the way the U.S. IVF industry does business. Indeed, ordinary IVF could be practiced in a way that would not result in the destruction of human embryos; in Germany, for instance, it is illegal to create “excess” embryos during IVF treatments.
Another objection to these new techniques relates to the risks they will pose to the created children. While there have been a few preliminary studies, the risks are still poorly understood. Against these critics, Berezow writes that “a mother with a mito-chondrial disease who wishes to have her own children may very well choose to accept the risk.” Indeed she may, but the child born through this experimental procedure is obviously in no position to accept the risk.
There is one other frequently raised objection to these technologies that seems misguided, namely, that they are a form of “genetic engineering” or, as bioethicist Margaret Somerville put it in a column for the Ottawa Citizen, that they would be a form of inheritable genetic engineering. Children who are created using these methods would pass their modified genes on to their children. Rather than worrying about whether using a new technology might give future generations different genetic characteristics than they would otherwise have inherited, we should be concerned about the way genetic engineering can alter the relationship between the generations from one of parents accepting the novelty and spontaneous uniqueness of their children to one where parents use biotechnology to choose and control the biological nature of their children.
That said, it is far from clear that these new techniques enable such morally problematic technological mastery. In a debate held earlier this year on whether genetic engineering should be prohibited, Duke law professor Nita Farahany argued that these new techniques will not lead “to a dystopia of designing perfect babies,” emphasizing that they would simply prevent the transmission of various disease-causing genes to give parents healthy children. The aim of giving parents babies that are genetically related to them but free of debilitating heritable diseases is perfectly understandable, and not one that should be confused with the morally twisted aims of eugenics or of the specter of “designer babies.”
Ironically, Farahany’s opponents in the debate, who argued that genetic engineering should be prohibited, pointed to pre-implantation genetic diagnosis (PGD) as a morally acceptable alternative. PGD allows doctors and parents to test embryos prior to implanting them, allowing them to select those with the “best” genes. For the most part, PGD aims simply to give parents children who are healthy, rather than perfectly designed. But PGD can also be used to select for any number of genetic traits, and is often used to select the sex of the embryo, a clear case of using technology to control important biological characteristics of the next generation.
And even beyond technologies like PGD, some forms of genetic control are already exercised through existing reproductive technologies and practices, such as finding and paying young women with high SAT scores for their eggs. But the fact that our society already engages in forms of genetic control that are arguably more serious and problematic than what these new procedures would offer does not, of course, justify embarking on these experimental reproductive technologies. Rather, the prospect of genetic engineering that these new ways of manipulating embryos and their DNA raise helps us to see what is morally problematic in the existing technologies.
Let’s return to the most shocking aspect of these techniques, the fact that they create children with three parents. Defenders may say we already do something similar with egg and embryo donation or in surrogacy arrangements. In these cases, the child has a genetic mother and a genetic father but also a gestational mother, who carries the child to term but is not genetically related. But even though gestation is not a form of genetic parenthood, it is hard to deny that being pregnant for nine months creates an important biological, not to say emotional and personal, tie with the child.
Again, it would seem that we have come to accept arrangements that split apart the various biological and social aspects of parenthood, and that deliberately create families where children will never know one or both of their genetic parents. But do these practices justify carving up parenthood into even finer parts with these new methods that create three-parent embryos?
Perhaps the disquiet we feel when we hear about the creation of embryos with three parents should lead us to reconsider whether these other technological distortions were morally justifiable in the first place. Evidence collected in a 2010 report from the Institute for American Values suggests that donor-conceived children may experience serious emotional suffering as a result of the circumstances of their conception and the confusion surrounding their identity.
A common rhetorical strategy for defending controversial new biotechnologies is to point out that there are plenty of things we already do that are morally problematic and to argue that, for the sake of consistency, we should accept the new technology as well. Consistency is obviously important, but we should strive to be consistently good, not consistently base, and we should not assume that our horror at something new is ill-founded simply because we realize that what we find horrible is already all around us.
The repugnance that we feel when we contemplate new biotechnologies that violate the natural order of the family may indeed be, as Leon Kass famously argued, a source of deep wisdom that can help guide us through the possibilities that the future has in store. As we consider the mixed blessings of the biotechnology project that society has already grown to accept, we should reflect on how our reactions to what seems shocking and new can bring renewed clarity to the moral meaning of what has become all too familiar
Brendan P. Foht is assistant editor at the New Atlantis: A Journal of Technology and Society.